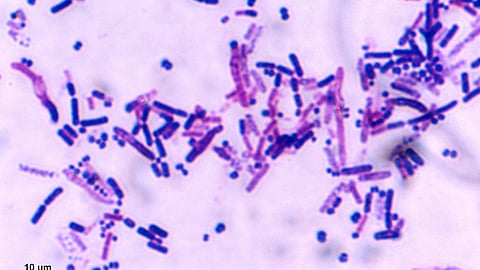

A 75-year-old man from Kerala was diagnosed with murine typhus on October 11, following his recent travel to Vietnam and Cambodia. After returning from his trip, the patient experienced fatigue and body pain, seeking medical attention on September 8. Initial tests for rat and flea-borne diseases were inconclusive, although doctors noted that his liver and kidney functions were declining. Based on his travel history, murine typhus was suspected and later confirmed using Next Generation Sequencing (NGS) technology. This marks the first reported case of the disease in Kerala.
What Is Murine Typhus?
Murine typhus is a bacterial disease caused by Rickettsia typhi, transmitted to humans via bites from infected fleas. Known by other names such as endemic typhus or flea-borne typhus, the bacteria often infect rodents like rats, mice, and mongooses. Infected fleas can also live on pets such as cats and dogs, spreading the disease throughout their lifespan.
The infection occurs when flea feces come into contact with cuts, scrapes, or mucous membranes. However, it cannot spread from person to person or from humans to fleas. In India, murine typhus has been previously reported in regions like the Northeast, Madhya Pradesh, and Kashmir, with cases more common in tropical coastal areas where rodents thrive.
Symptoms of Murine Typhus
Symptoms typically appear 7 to 14 days after exposure. These may include fever, headache, muscle and joint pain, nausea, vomiting, and abdominal discomfort. Some patients may develop rashes a few days after the initial symptoms. Although the illness usually lasts two weeks, complications can arise if untreated, prolonging recovery and, in rare cases, becoming life-threatening.
In the Kerala case, the diagnosis was confirmed by additional testing at Christian Medical College (CMC), Vellore, after NGS analysis identified microbial DNA consistent with murine typhus.
Treatment and Prevention
Currently, no vaccine exists for murine typhus. The recommended treatment is the antibiotic doxycycline, which is most effective when administered early. Without timely intervention, the condition can worsen within one to two weeks, occasionally becoming fatal.
Prevention primarily focuses on flea control. Households with pets should practice regular cleaning and monitor for signs of flea infestations. If fleas are detected, appropriate treatment should be carried out to prevent transmission of the disease.
(Input from various sources)
(Rehash/Ankur Deka/MSM)